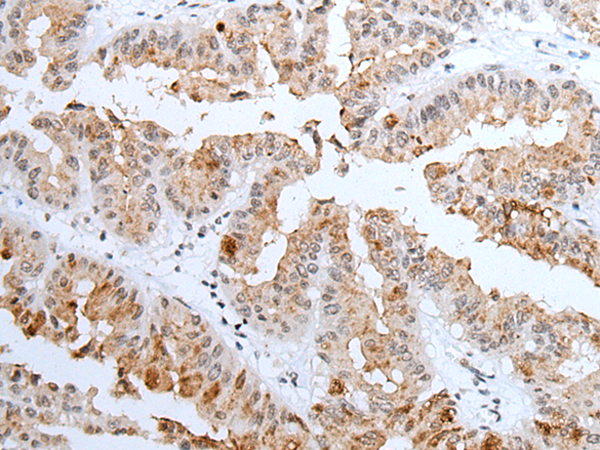

抗 原: IRAK1
反應(yīng)種屬: Human
技術(shù)規(guī)格
Background:
This gene encodes the interleukin-1 receptor-associated kinase 1, one of two putative serine/threonine kinases that become associated with the interleukin-1 receptor (IL1R) upon stimulation. This gene is partially responsible for IL1-induced upregulation of the transcription factor NF-kappa B. Alternatively spliced transcript variants encoding different isoforms have been found for this gene.
Applications:
ELISA, IHC
Name of antibody:
IRAK1
Immunogen:
Synthetic peptide of human IRAK1
Full name:
interleukin 1 receptor associated kinase 1
Synonyms:
IRAK; pelle
SwissProt:
P51617
ELISA Recommended dilution:
5000-10000
IHC positive control:
Human liver cancer and human thyroid cancer
IHC Recommend dilution:
25-100

購(gòu)物車
幫助
021-54845833/15800441009
